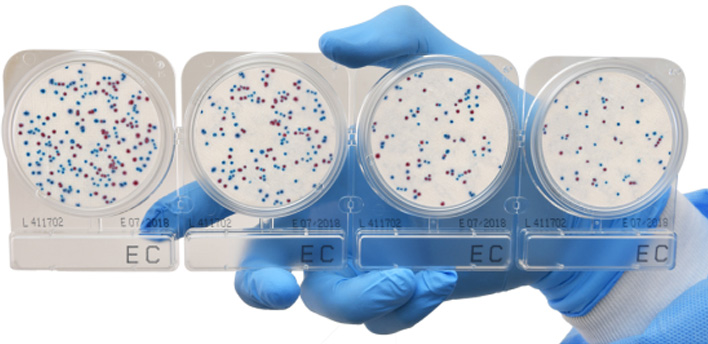
Picture of Compact Dry™ Prepared Media Plates

Products
Microbiology
Filter by subcategory
No products found

Interscience Scan® Automatic Colony Counters
Please Contact Us for a Quote View Details

Phoenix Star™Dish 100 x 15 mm Sterile Semi-Stackable Sectional Petri Dishes
From $149.23 View Details